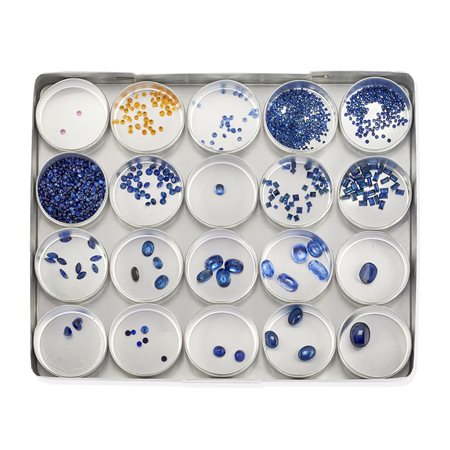
Cofanetto con zaffiri, blu, gialli e rosa
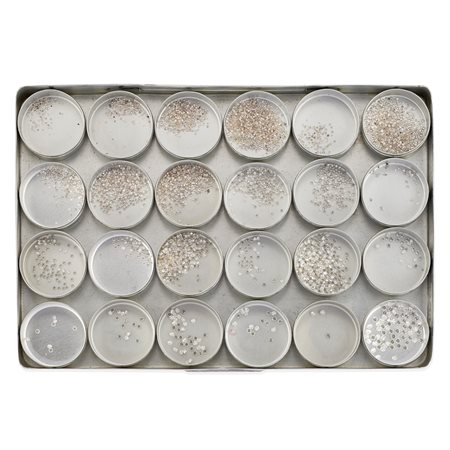
Cofanetto con diamanti

Gioielli e Argenti
-

Lot 625 Orecchini con cammeo e perle
in oro giallo 18K con cammeo raffigurante profilo femminile in pasta di pietra dura rossa e perle scaramazze pendenti, chiusura a monachella.
Peso g 17,20 cm 6,00
-

Lot 626 Collana con perle coltivate, cristallo di rocca, onice e diamanti
in oro giallo 18K, a due fili di perle coltivate di mm 7,50/8,00, onice, cristallo di rocca e diamanti.
Peso g 106,20 cm 40,00
-

Lot 627 Orecchini con giaietto
in oro giallo 18K e giaietto nero intarsiato a motivo floreale, collezione "Victoria", a fascia, con chiusura a monachella.
Peso g 12,10 cm 6,00x3,00
-

Lot 628 Orecchini con giaietto
in oro giallo 18K satinato, a creola di forma ovale con giaietto nero, collezione "Victoria", chiusura con perno e scatto.
Peso g 18,50 cm 4,00x2,50
-

Lot 629 Demi-parure con rubini
in oro giallo 18K, rubini taglio cabochon per totale ct 4,00 circa, composta da collana e orecchini con foglie incise.
Peso g 75,10 cm 46,00 cm 2,50
-

Lot 630 Collana con granato
in oro giallo 18K, ad un filo di boules.
Peso g 50,20 cm 90,00
-

Lot 631 Orecchini pendenti con quarzi
in oro rosso 9K, realizzati a doppio corpo con quarzi briolette, con chiusura a baionetta.
Peso g 10,30
-

Lot 632 Collana con giadeite
in oro giallo 18K, a cinque fili di boules in giadeite con catenella e pendente granfiato.
Peso g 48,50 cm 40,00
-

Lot 633 Collana in oro
rosso 9K, con "chiacchiere".
Peso g 52,00 cm 127,00
-

Lot 634 Collana con perle, rubini e madreperla
realizzata a dieci fili di perle coltivate, rubini e madreperla, a torchon.
Peso g 77,40 cm 44,00
-

Lot 635 Anello con diamanti e ametista
in oro rosso 18K, con ametista rotondo sfaccettato di ct 14,00 circa e diamanti taglio brillante per totale ct 0,45 circa.
Peso g 13,50 misura 15
-

Lot 636 Anello con cristallo di rocca, quarzo e diamanti
in oro bianco 18K, con cristallo di rocca taglio ovale briolette e fiori in diamanti e quarzo citrino.
Peso g 19,30 misura 15
-

Lot 637 Orecchini con madreperla e diamanti
in oro bianco 18K, con motivo ad onda in madreperla e diamanti taglio brillante per totale ct 0,70 circa.
Peso g 16,40
-

Lot 638 Collana con rubini
ad un filo di sfere di rubini taglio cabochon da mm 6,80-3,00 circa per totale ct 340,00 circa.
Peso g 68,50 cm 175,00 circa
-

Lot 639 Anello con diamanti e pietre dure
in oro bianco 18K, di forma ovale con motivo ad intarsi in onice, agata bianca e quarzo rosa, rifinito in diamanti neri per totale ct 0,50 circa.
Peso g 28,00 misura 15
-

Lot 640 Bracciale con diamanti
in oro bianco 18K e diamanti taglio huit-huit, alla schiava.
Peso g 53,80 diametro cm 6,00
-

Lot 641 Cofanetto con diamanti brown, neri e incolori
taglio brillante e fantasia per totale ct 32,95; suddivisi in ventiquattro scatolette: diamanti brown taglio brillante ct 17,15, diamanti neri taglio brillante ct 13,16, diamanti incolori taglio fantasia ct 2,64.
Totale ct 32,95
-

Lot 642 Cofanetto con smeraldi
di tagli diversi per totale ct 109,02; suddivisi in venti scatolette: taglio brillante ct 17,39 incisi a foglie ct 66,26, cabochon ovale ct 2,08, taglio cuore ct 2,18, taglio ovale ct 1,25, taglio carré ct 2,30, taglio rettangolare ct 14,28.
Totale ct 109,02
-
Lot 643 Cofanetto con zaffiri, blu, gialli e rosa
di tagli diversi per totale ct 94,95 suddivisi in venti scatolette: colore rosa taglio brillante ct 0,14, colore giallo taglio brillante ct 2,61, blu: taglio brillante ct 40,37, taglio carré ct 3,19, taglio rettangolare ct 6,14, taglio marquise ct 2,07, taglio ovale ct 24,38, taglio cuore ct 1,42, taglio tondo cabochon ct 0,61, taglio ovale cabochon ct 14,02.
Totale ct 94,95
-

Lot 644 Cofanetto con rubini
di tagli diversi per totale ct 72,10, suddivisi in venti scatolette: taglio brillante ct 14,36, taglio goccia ct 0,28, taglio marquise ct 5,98, taglio carré ct 4,03, taglio ovale ct 11,03, taglio cuore cabochon ct 1,75, taglio ovale cabochon ct 34,67.
Totale ct 72,10
-
Lot 645 Cofanetto con diamanti
taglio brillante per totale ct 49,09, suddivisi in ventiquattro scatolette: setacci da 0,00 a 2, ct 13,52 (media ct 0,01) setacci da 2,5 a 6,5, ct 19,09 (media ct 0,02) setacci da 7 a 11, ct 16,53 (media da ct 0,03 a ct 0,07).
Totale ct 49,09
-

Lot 646 Orologio sveglia da viaggio in acciaio
movimento al quarzo, numeri romani, di forma quadrata, con astuccio in pelle nera e astuccio Cartier (condizioni pari al nuovo).
Peso g 149,00 cm 5,50 x 5,50
-

Lot 647 Ciotola con cristallo
di forma tonda a decoro sfaccettato.
Peso g 421,70 diametro cm 15,50 -

Lot 648 Orologio da donna in oro rosso 18K
cassa rotonda, quadrante chiaro con indici e numeri romani applicati, movimento a carica manuale.
Peso g 23,30 cm 17,00
